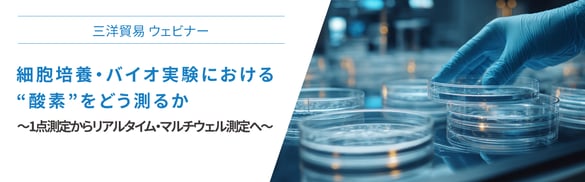
presens_oxy_20260121_webinar_banner

| テーマ |
|
| 開催日時 |
2026年1月21日(水)14:00~14:50 |
| 配信方法 |
オンライン(Zoomウェビナー) |
| 概要 |
ウェビナー概要細胞培養や創薬研究において、酸素は細胞機能や代謝、薬剤応答に大きな影響を与える重要なパラメータです。一方で、多くの実験ではインキュベーターの設定値を前提とした運用がなされており、細胞が実際に曝露されている酸素環境は十分に把握されていないのが現状です。 アジェンダ・導入~バイオ実験における酸素測定の見落とされがちな問題~ 言語日本語 参加費無料 ウェビナーのお申し込みはこちら |